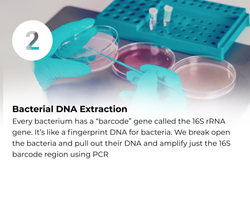
2

top of page
Our Services

Our approach focuses on a holistic, animal-centered design, ensuring the highest standards for animal health and welfare. We prioritize the well-being of every racehorse.

Precision Microbiome Analysis
Comprehensive analysis of your horse's gut microbiome, providing detailed insights into microbial diversity, health markers, and performance indicators.
-
Health and performance biomarkers
-
Personalized recommendations
-
Progress tracking over time

Targeted Probiotics
Precision-formulated probiotic solutions designed to address specific conditions and optimize your horse's microbiome for peak performance. Currently under development and a key focus of our R&D efforts.
-
Condition-specific formulations
-
Science-backed probiotic strains
-
Quality-assured manufacturing
-
Ongoing support and monitoring
bottom of page